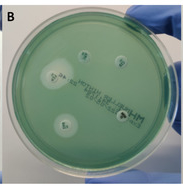

Differences in Antimicrobial Testing Techniques: Classical and Modern Methods

Since the discovery of the antibiotic penicillin by Alexander Fleming, antimicrobial testing has become a new method for identifying substances capable of killing pathogenic bacteria. As technology has advanced, antimicrobial testing methods have also evolved.
However, the main problem today is that there are many synthetic and natural materials claimed to have antimicrobial effects, but their effectiveness has not yet been scientifically proven. After the COVID-19 pandemic, the use of antibiotics, disinfectants, hand sanitizers, and surface cleaners increased significantly.
This is expected to accelerate the emergence of microbes resistant to antimicrobial agents in the future. As a result, patients may need to use more expensive medications or undergo longer treatments.
One of the key steps to address this problem is the implementation of antibiotic use control programs. While simple methods such as diffusion or dilution tests are still commonly used, antimicrobial testing technology has become increasingly advanced.
- What Is Antimicrobial Testing?
- Classical Methods of Antimicrobial Testing
- Modern Methods of Antimicrobial Testing
What Is Antimicrobial Testing?
Antimicrobial testing is a laboratory procedure carried out by medical laboratory scientists to determine which types or combinations of antibiotics are most effective for each patient. This testing also helps evaluate the quality of medical products used in hospitals or clinics to prevent infectious diseases.
Clinical laboratories generally use classical methods such as the disk diffusion method and determination of the Minimum Inhibitory Concentration (MIC). Meanwhile, some hospitals and health centers now have automated commercial systems that use phenotypic and genotypic approaches to identify bacterial resistance.
Classical Methods of Antimicrobial Testing
1. Dilution Method
The dilution method is considered the reference standard because it allows researchers to determine the Minimum Inhibitory Concentration (MIC)—the lowest concentration of an antimicrobial substance that can inhibit bacterial growth—or the Minimum Bactericidal Concentration (MBC)—the lowest concentration that can kill 99.9% of bacteria.
The MIC value serves as a reference for determining bacterial resistance to specific antibiotics. This method is used when disk diffusion zone standards are not applied. The main difference is that disk diffusion gives qualitative results, while dilution provides quantitative results, showing how strong or weak bacteria are against a particular antibiotic.
2. Antimicrobial Gradient Method

Sumber Jurnal “Antimicrobial Susceptibility Testing:
A Comprehensive Review of Currently Used Methods”
The gradient strip test is a hybrid method that combines disk diffusion and dilution techniques. This method is simple to perform like disk diffusion, but it can also determine the MIC value.
The principle is that the antibiotic diffuses through the agar medium in a gradual concentration gradient. The MIC is determined by the point where the inhibition zone intersects with the concentration scale on the strip.
Commercial gradient strip products currently available include Etest (bioMérieux, France), MIC Test Strip (Liofilchem, Italy), M.I.C. Evaluator (Thermo Scientific, USA), and Ezy MIC Strip (HiMedia Laboratories, India).
3. Disk Diffusion Method
Sumber Jurnal “Antimicrobial Susceptibility Testing:
A Comprehensive Review of Currently Used Methods”
This is the most commonly used method in clinical microbiology laboratories to test antimicrobial activity. It has been standardized to detect various types of bacteria that cause human diseases.
The principle is simple: antibiotic-impregnated paper disks are placed on the surface of an agar medium that has been inoculated with bacterial suspension. The antibiotic diffuses outward in a circular pattern, forming a clear inhibition zone where bacterial growth is prevented.
Although this method is inexpensive and easy to perform, it does not provide the MIC value. The results are qualitative, based on the diameter of the inhibition zone formed around the disk.
Modern Methods of Antimicrobial Testing
1. Automated and Semi-Automated Microdilution Systems
These instruments are designed to identify bacteria and improve laboratory efficiency. They use optical systems to detect subtle changes in bacterial growth. Since they employ advanced equipment, they can generate results within 6–12 hours.
However, the limitations include possible false positive results when the bacterial inoculum is too low. In addition, regular software updates and standard calibration according to the latest guidelines are required to maintain accuracy.
2. Molecular-Based Techniques
Molecular antimicrobial testing works by directly detecting resistance genes, including gene mutations and expressions that make bacteria resistant to antibiotics. The main advantage of this method is its rapid turnaround time, with results available in as little as one hour.
3. Polymerase Chain Reaction (PCR)
The most commonly used nucleic acid amplification method for detecting resistance genes is PCR (Polymerase Chain Reaction). Both conventional and real-time PCR work by amplifying DNA fragments that contain genes responsible for antibiotic resistance. An advantage of PCR is its ability to detect non-beta-lactam resistance genes, including those responsible for resistance to last-resort antibiotics such as colistin.
Advances in technology have brought significant changes to how scientists test microbial sensitivity to antibiotics. From classical methods like disk diffusion to modern molecular-based techniques, each plays an essential role in combating antimicrobial resistance. By integrating faster, more accurate, and sustainable technologies, we can be better prepared to face the growing threat of antibiotic-resistant bacteria in the future.
Read more:
Flawless Disease Detection with Polymerase Chain Reaction (PCR) and Molecular Diagnostics!
Amid the increasing use of antibiotics and disinfectants in the post-pandemic era, the challenge of antimicrobial resistance is no longer merely a clinical issue, but also a matter of product quality, safety, and effectiveness. Various antimicrobial testing methods, both classical and modern, offer different approaches to assessing microbial susceptibility.
However, without proper laboratory testing, claims of antimicrobial effectiveness risk becoming mere assumptions. This is where antimicrobial testing plays a crucial role in ensuring that every antibiotic, disinfectant, or antimicrobial product truly performs as intended.
Ensure that antimicrobial effectiveness is not based solely on claims, but is proven through standardized laboratory testing. Test with IML Testing and Research to obtain accurate, comprehensive, and reliable antimicrobial testing results that support resistance control and product quality improvement.
Author: Safira
Editor: Sabilla Reza
References:
Bayot ML, Bragg BN. Antimicrobial Susceptibility Testing. [Updated 2024 May 27]. In: StatPearls [Internet]. Treasure Island (FL): StatPearls Publishing; 2025 Jan-. Available from: https://www.ncbi.nlm.nih.gov/books/NBK539714/
Gajic, I.; Kabic, J.; Kekic, D.; Jovicevic, M.; Milenkovic, M.; Mitic Culafic, D.; Trudic, A.; Ranin, L.; Opavski, N. Antimicrobial Susceptibility Testing: A Comprehensive Review of Currently Used Methods. Antibiotics 2022, 11, 427. https://doi.org/10.3390/antibiotics11040427



